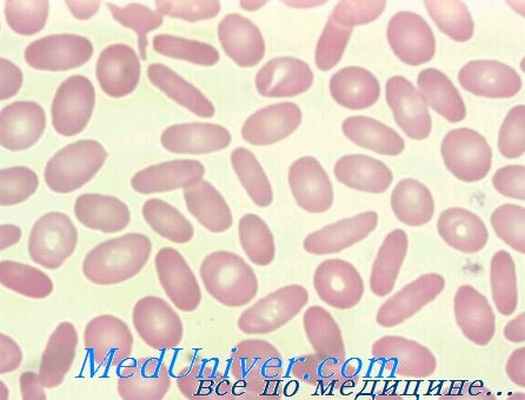
мазок при наследственном овалоцитозе

Наследственный сфероцитоз и наследственный эллиптоцитоз
Добавил пользователь Alex Обновлено: 27.01.2026
Наследственный овалоцитоз (врожденный эллиптоцитоз): клиника, диагностика, лечение
Наследственный овалоцитоз (синоним — врожденный эллиптоцитоз) врожденная болезнь, характеризующаяся наличием высокого процента овальных эритроцитов в периферической крови, с нередко сопутствующей анемией гемолитического вида.
История изучения наследственного овалоцитоза. Впервые болезнь описал Dresbach в 1904 г. на 22-летнем заболевшем мулатре. В 1914 г. Bishop описал ее семейный характер a Wyandtn сотр. (1941) ссылаются на 246 описанных в литературе случаев в 64 семьях. С тех пор в литературе публикуются довольно частые случай разнообразных клинических форм.
Этиология и патогенез наследственного овалоцитоза. Болезнь носит наследственный характер, передается как доминантная черта и в одинаковой мере поражает лиц обоего пола. Поскольку речь идет о доминантном гене, в принципе проникновение болезни должно быть 100%, даже и в тех случаях, когда один из родителей здоров.
Тем не менее бывает и так, что, на вид, данное лицо здорово, хотя один из родителей (передающий отягчение) и ряд других его детей больны. Это подсказывает мысль о возможно неполном проникновении, а в связи с этим и селективной выраженности доминантного гена.
Описано также наличие линкажа эллиптоцитоза с резусгенотипом, поскольку оба расположены по соседству в том же хромосоме.
Морфофункциональная почва аномалии не вскрыта, видимо она находится в оболочке эритроцита (Piguet и сотр.).
Клинические признаки наследственного овалоцитоза
В 1950 г. Гейльмейер описал следующие три клинических вида эллиптоцитоза — без гемолиза, с компенсированным гемолизом и декомпенсированным гемолизом.
В большинстве случаев (80—90%) эллиптоцитоз протекает как латентное заболевание, без клинических признаков, обнаруживается случайно при семейных анкетах или прочете гемограммы.
В отдельных случаях эллиптоцитоза отмечается сокращение продолжительности жизни эритроцитов и компенсаторная реакция костного мозга, которая отражается в повышении целлюлярности, наличии завышенного числа нормально созревающих эритробластов, высоком показателе ретикулоцитов в периферической крови и мало повышенном косвенном билирубине.
Отсутствуют анемия и желтушная окраска. Однако описаны виды эллиптоцитоза с полиглобулией.
В иных случаях (5—10%, в зависимости от автора) отмечается одновременное наличие скрытой анемии и приступов преходящей деглобулизации, подобно обнаруживаемых при наследственном сфероцитозе. Описаны и случаи роствовесовых и соматопсихических сдвигов, подобно наблюдаемых при тяжелых формах внутриэритроцитной гемолитической анемии.
Выраженно эллиптическая форма этих эритроцитов нарушает внутриселезеночное кровообращение; были и явные случаи селезеночной секвестрации, при которых спленэктомия сокращала гемолиз.
Лабораторные признаки наследственного овалоцитоза
Наличие невысокого процента овалоцитов (1—15%), между продольным и поперечным диаметром которых разница невелика (8u/6u) можно рассматривать как физиологический факт. При наследственном овалоцитозе число эллиптических эритроцитов завышено, при этом разница между диаметрами может оказаться существенной (бактериоциты).
В случаях умеренной формы заболевания их численность не составляет более 20—30%, в то время как при тяжелых — превышает 90%. Костномозговые предшественники эритроцитов имеют нормальный вид, овалоцитоз развивается лишь после стадии ретикулоцита.
Терапия наследственного овалоцитоза
Заболевание, в котором отсутствуют клинические признаки, не требует лечения и его следует рассматривать в основном как гематологическая странность.
В гемолитических и развивающих анемию случаях лечение одинаково с наследственным сфероцитозом - в основном спленэктомия.
Редактор: Искандер Милевски. Дата обновления публикации: 18.3.2021
Информация на сайте подлежит консультации лечащим врачом и не заменяет очной консультации с ним.
См. подробнее в пользовательском соглашении.
18. НАСЛЕДСТВЕННЫЙ СФЕРОЦИТОЗ, ЭЛЛИПТОЦИТОЗ
Наследственный сфероцитоз (НС) (болезнь Минковского-Шоффара) — генетическое заболевание, сопровождающееся гемолизом различной интенсивности, снижением осмотической резистентности эритроцитов, сфероцитозом, спленомегалией и желтухой.
• Повышенная деструкция эритроцитов является результатом дефицита или патологии одного, либо нескольких белков мембраны эритроцитов.
• В таблице 18.1. представлены различные структурные и метаболические нарушения
эритроцитов при НС.
Патология эритроцитов при врожденном сфероцитозе
Частичный дефект спектрина Комбинированный дефект спектрина и анкирина Частичный дефект цепи протеина 3 Дефицит протеина 4.2 и другие дефекты Измененные свойства мембраны эритроцитов Потеря клеточной поверхности Изменения липидов мембраны Изменение содержания кальция Изменения структуры белков мембраны
Повышение содержания мембран-связанной каталазы Hb Нарушение фосфорилирования белков Дефект белковой агрегации Дефект присоединения протеина 4.1
Изменение клеточного катаболизма
Повышение проницаемости натрия Усиление гликолиза Сниженный транспорт фосфоэполпирувата
ЧАСТИЧНЫЙ ДЕФИЦИТ СПЕКТРИНА
• При доминантно-наследуемом НС мутация локализуется в конверсируемой области b - спектрина, который в норме присоединяется к протеину 4.1, но вследствие дефицита спектрина этот процесс нарушается.
• При рецессивно-наследуемом НС мутация локализуется в области a -спектрина.
КОМБИНИРОВАННЫЙ ДЕФИЦИТ СПЕКТРИНА/АНКИРИНА
• Наблюдается потеря или снижение экспрессии генов анкирина, который является первичной цепью присоединения спектрина на мембране. При его потере или снижении наблюдается пропорциональное уменьшение содержания спектрина.
ЧАСТИЧНЫЙ ДЕФИЦИТ ЧАСТИ ПРОТЕИНА 3
• Доминантно-наследуемое заболевание, которое характеризуется присутствием в крови эритроцитов в виде «пинцета». По мере увеличения срока жизни эритроцитов, дефицит протеина 3 усиливается, что свидетельствует о нестабильности этого протеина.
ДЕФИЦИТ ПРОТЕИНА 4.2
• В данном случае наблюдается несколько мутаций.
• При дефиците спектрина происходит потеря липидов в мембране эритроцитов.
• Активный транспорт натрия из эритроцитов компенсаторно повышается, но относительный избыток Na + внутри клеток приводит к повышенному накоплению в них воды.
• Уменьшение площади эритроцита и уплотнение цитоплазмы способствуют нарушению
способности к деформации (эластичности мембраны) эритроцитов при прохождении клеток через селезеночные синусы. При каждом прохождении клеток через селезенку эритроциты подвергаются воздействию ряда неблагоприятных факторов; в частности, так называемому «улавливающему эффекту», при котором происходит потеря части мембраны эритроцита, края мембраны эритроцита соединяются, эритроцит вновь поступает в кровяное русло.
• Утрата части оболочки и поверхности клетки приводит к постепенному уменьшению эритроцита. При достижении определенных изменений в структуре оболочки эритроци-
тов они поглощаются макрофагами селезенки.
• Для НС характерна клиническая триада:
• анемия различной степени выраженности.
• Симптомы и клинические проявления НС очень вариабельны и зависят от тяжести и возраста, при котором они впервые появились.
• В отдельных случаях НС анемия может отсутствовать, вследствие компенсаторного повышения продукции эритроцитов в КМ после массовой клеточной деструкции.
• Анемия обычно умеренная.
• Желтуха наиболее выражена у новорожденных.
• Характерно, что желтуха является перемежающейся и связана с недомоганием, воздействием холода, эмоциональным стрессом, беременностью. При отсутствии провоцирующих факторов желтуха у больных может не наблюдаться.
• У 75-80 % больных наблюдается значительное увеличение размеров селезенки.
• Размеры печени и ее функция обычно не нарушены.
• Изменения морфологии клеток могут быть незначительными; уровень билирубина и количество ретикулоцитов остаются нормальными или несколько повышенными.
ОСЛОЖНЕНИЯ НАСЛЕДСТВЕННОГО СФЕРОЦИТОЗА
• Апластические кризы вследствие парвовирусной инфекции вызывают транзиторную
ретикулоцитопению и падение Ht.
• Усиление гемолиза отмечается при инфекции, однако гемолиз
• Желчнокаменная болезнь развивается приблизительно у 50 % больных.
• Рецидивирующие дерматиты и изъязвления кожи наблюдаются
• Повышение запасов железа развивается в результате частых трансфузий и иногда вызывает тяжелые осложнения.
• Если заболевание имеет клинические проявления с детского возраста, то наблюдаются деформации скелета: башенный квадратный череп, высокое небо, укорочение мизинцев.
• Степень анемии варьирует в зависимости от тяжести заболевания. Полностью компенсированная анемия наблюдается у 25 % больных.
• Кровь: МСН и MCV, цветовой показатель могут быть нормальными, повышенными или
сниженными. МСНС повышен приблизительно у 50 % больных.
• Выраженный ретикулоцитоз наблюдается практически у всех больных.
• Количество лейкоцитов и тромбоцитов нормальное, повышается после спленэктомии.
• В мазках крови отдельные эритроциты выглядят как микросфероциты— эритроциты меньших, чем в норме, размеров без центрального просветления, гиперхромные, как результат клеточной дегидратации.
• В мазках крови обнаруживается полихромазия, пойкилоцитоз, но редко встречаются ядросодержащие эритроциты.
• Повышенная деструкция эритроцитов при НС приводит к увеличению концентраций сывороточной ЛДГ, непрямого билирубина, снижению содержания сывороточного гаптоглобина и повышению концентрации уробилиногена в моче.
• Снижение осмотической резистентности эритроцитов: эритроциты при НС быстро гемолизируются в гипотоническом растворе хлорида натрия. Этот лабораторный признак характерен для лиц с интактной селезенкой.
• При иммунном гемолизе и присутствии нестабильногоHb в эритроцитах в мазках крови могут присутствовать сфероциты. Сфероцитоз появляется также у больных с увеличенной селезенкой или при МАГА. Однако при НС сфероциты являются однородными и обусловливают повышение показателя МСНС.
• Наследственный сфероцитоз следует исключать у лиц со случайно обнаруженной спленомегалией и при желчнокаменной болезни в молодом возрасте.
• Диагноз НС может быть замаскирован у больных с обструктивной желтухой, при которой эритроциты, вследствие накопления холестерина и фосфолипидов, могут вновь приобретать нормальную морфологию.
• Дефицит железа у больных НС также может способствовать нормализации формы и осмотической резистентности эритроцитов, но продолжительность жизни эритроцитов остается сниженной.
• Синдром Жильбера может быть исключен при исследовании формы эритроцитов и их осмотической резистентности.
ТЕРАПИЯ, ТЕЧЕНИЕ, ПРОГНОЗ
• Вследствие повышенного разрушения эритроцитов в терапию необходимо включать фолиевую кислоту.
• Больным с апластическими кризисами или тяжелым гемолизом показаны трансфузии эритроцитарной массы.
• Спленэктомия обычно корригирует анемию, но у некоторых больных продолжитель-
ность жизни эритроцитов остается укороченной. При
мия только частично уменьшает гемолиз.
• Спленэктомия не показана больным с асимптоматическим течением
Операция обычно проводится у лиц с наличием
частых трансфузий или желчнокаменной болезни.
• При наличии сопутствующих заболеваний, особенно дефицита пируваткиназы, спленэктомия может оказаться неэффективной.
• Спленэктомия обычно проводится после 6-ти летнего возраста вследствие высокой частоты развития инфекционных осложнений у детей младшего возраста.
НАСЛЕДСТВЕННЫЙ ЭЛЛИПТОЦИТОЗ И СВЯЗАННЫЕ ЗАБОЛЕВАНИЯ
• наследственный эллиптоцитоз с дискоидальными эллиптоцитами;
• сфероцитарный или овалоцитарный НЭ;
• наследственный эллиптоцитоз с наличием стоматоцитов (называемый также меланезийским или южно-азиатским овалоцитозом), при котором эритроциты имеют округлую форму с неокрашенным участком в центре эритроцита, ограниченным двумя изогнутыми линиями, соединенными по бокам.
ЭТИОЛОГИЯ И ПАТОГЕНЕЗ
• Аутосомно-доминантно-наследуемая аномалия эритроцитов, при которой наиболее характерными молекулярными дефектами являются мутации в a -и b -спректрине. Регистрируется дефицит или дисфункция протеина 4.1.
• Дефицит гликофорина С может появляться вследствие отдельных молекулярных -де фектов. У лиц гомозиготных по гликофорину ,С наблюдается эллиптоцитоз без анемии.
• Эритроцитарные предшественники при НЭ имеют округлую форму: эритроциты приобретают эллиптоидную форму только при выходе из КМ. Предполагается, что эритроциты при НЭ постоянно стабилизированы на их патологическую форму реорганизацией скелетона при контакте клеток с новыми белками (сыворотка крови).
• Транзиторный гемолиз у больных НЭ возникает после вирусной, бактериальной или протозойной инфекций, отторжении почечного трансплантанта, дефиците витамина В12, беременности.
• У новорожденных с НЭ наблюдается тяжелая гемолитическая анемия в течение первого года жизни. Дестабилизация патологически измененной мембраны у них является следствием повышения содержания 2,3-бис-фосфоглицерата, который слабо присоединяется к фетальному Hb. При понижении концентрации фетального Hb интенсивность гемолиза понижается.
• У гетерозигот, имеющих выраженную мутацию альфа-спектрина, а также гомозигот с дефицитом белка 4.1 или мутацией бета-спектрина наблюдается выраженный гемолиз, желчнокаменная болезнь, изъязвление кожи голеней, изменения костей скелета. Наряду с эллиптоцитозом у этих больных в мазках крови обнаруживают значительное количество пойкилоцитов и фрагментированных эритроцитов.
• При НЭ с минимальными или средними проявлениями гемолиза в мазках крови присутствуют эллиптоциты, продолжительность жизни которых может быть нормальной.
• Диагноз эллиптоцитоза основан на обнаружении характерной формы эритроцитов и увеличения количества пораженных клеток. Процент эллиптоцитов у здоровых лиц не превышает 5 %. Наличие семейного анамнеза имеет более весомое значение для диагностики НЭ, чем морфологическое исследование эритроцитов и подсчет количества эллиптоцитов.
• Осмотическая резистентность эритроцитов при умеренном НЭ остается нормальной, но снижена при тяжелом НЭ и сферотическом НЭ.
НАСЛЕДСТВЕННЫЙ ПИРОПОЙКИЛОЦИТОЗ (НПП)
Аутосомно-рецессивное заболевание, характеризующееся мутацией альфа-спектрина и дефицитом синтеза спектрина. Сопровождается тяжелой гемолитической анемией, выраженным микросфероцитозом и микропойкилоцитозом (MCV ниже 50 П), а также термической нестабильностью эритроцитов.
• Анемия (содержание Hb у детей может снижаться до 50-55 г/л).
• Ретикулоцитоз. В мазках крови наличие микросфероцитов, анизо-, пойкилоцитоз, фрагментация, базофильная пунктация эритроцитов, эритробластоз.
• Снижение осмотической резистентности эритроцитов.
• У здоровых лиц денатурация спектрина и фрагментация эритроцитов происходит при 49-50°С. При НПП они развиваются при 45-46°С. При отдельных случаях НПП регистрируется нормальная температурная чувствительность.
• Лечение: спленэктомия не эффективна.
• Эллиптоциты и пойкилоциты в мазках крови обнаруживаются при многих заболеваниях: мегалобластной анемии, миелофтической анемии, МДС, дефиците пируваткиназы. Однако при этих состояниях число эллиптоцитов и пойкилоцитов редко превышает60 %. Дифференциальная диагностика НЭ основывается на отрицательном семейном анамнезе и наличии других клинических проявлений, характерных для основного заболевания.
• При умеренных клинических проявлениях заболевания лечение не проводится. При более тяжелых формах показана спленэктомия.
Наследственный сфероцитоз и наследственный эллиптоцитоз

Наследственный сфероцитоз и наследственный эллиптоцитоз относятся к врожденной патологии мембран эритроцитов, которые могут вызвать умеренную гемолитическую анемию. При наследственном эллиптоцитозе симптоматика, как правило, выражена умеренно и включает анемию различной степени, желтуху, спленомегалию. Диагностика основана на выявлении сниженной осмотической резистентности эритроцитов в сочетании с отрицательным результатом прямого антиглобулинового теста. В редких случаях у пациентов моложе 45 лет требуется выполнение спленэктомии.
Наследственный сфероцитоз (хроническая семейная желтуха; врожденная гемолитическая желтуха; семейный сфероцитоз, сфероцитарная анемия) – это аутосомно-доминантное заболевание с различной генной пенетрантностью. Спорадическими являются около 25% случаев. Наследственный сфероцитоз характеризуется наличием гемолиза эритроцитов сферической формы и анемии.
Наследственный эллиптоцитоз (овалоцитоз) – это редкое аутосомно-доминантное заболевание, при котором эритроциты имеют овальную или эллиптическую форму. Гемолиз обычно отсутствует либо невыраженный, анемия отсутствует либо легкой степени, исключение составляют некоторые гомозиготные пациенты с наследственным пиропойкилоцитозом.
Патофизиология
При обоих заболеваниях эритроцитарные аномалии обусловлены патологическими изменениями структуры мембранных белков.
При наследственном сфероцитозе поверхность клеточной мембраны уменьшается диспропорционально количеству внутриклеточного содержимого из-за утраты белков, связанных с клеточной мембраной. Уменьшение клеточной поверхности сопровождается нарушением пластичности эритроцитов, необходимой для прохождения микроциркуляторного русла селезенки, это приводит к внутриселезеночному гемолизу.
При наследственном эллиптоцитозе генетические мутации приводят к ослаблению цитоскелета клетки и ее деформации. Патологические формы эритроцитов захватываются и разрушаются в селезенке.
Клинические проявления
При наследственном сфероцитозе, симптомы и признаки, как правило, выражены незначительно. Анемия может быть настолько хорошо компенсирована, что не диагностируется до момента возникновения интеркуррентного вирусного заболевания, такого как парвовирусная инфекция, которое сопровождается транзиторным снижением продукции эритроцитов, вызывая апластический криз. Эти эпизоды могут иметь самоограничивающееся течение и разрешаются после излечения инфекции, в то время как другие случаи требуют неотложного лечения. В тяжелых случаях развивается умеренно выраженная желтуха, наблюдаются симптомы анемии. Спленомегалия возникает почти во всех случаях, однако крайне редко сопровождается абдоминальным дискомфортом. Може присутствовать гепатомегалия. Также обычным является холелитиаз (пигментные камни), что сопровождается характерной симптоматикой. В некоторых случаях наблюдаются врожденные аномалии скелета («башенный» череп, полидактилия). Как правило, данные симптомы присутствуют у одного или более членов семьи, однако в некоторых поколениях больные люди могут отсутствовать в связи с вариабельностью пенетрантности данного гена.
Клинические проявления наследственного эллиптоцитоза аналогичны таковым при наследственном сфероцитозе, однако с тенденцией к более легкому течению заболевания; может наблюдаться спленомегалия.
Диагностика
Мазок крови, анализ стойкости эритроцитов, анализ аутогемолиза эритроцитов и прямой антиглобулиновый тест (реакция Кумбса)
Наследственный сфероцитоз или наследственный эллиптоцитоз необходимо подозревать у пациентов с наличием гемолиза неясной этиологии (о чем свидетельствуют анемия и ретикулоцитоз), особенно при наличии спленомегалии, семейного анамнеза подобных проявлений или характерных значений эритроцитарных индексов.
При наследственном сфероцитозе, в связи с шаровидной формой эритроцитов и нормальным показателем среднего эритроцитарного объема (MCV), показатель среднего диаметра эритроцита ниже нормы, и эритроциты напоминают микросфероциты. Средняя концентрация гемоглобина эритроцитах (МСНС) увеличена. Количество ретикулоцитов составляет 15–30%, характерен лейкоцитоз.
При наследственном эллиптоцитозе, эритроциты, как правило, эллиптической или сигарообразной формы; однако клинические проявления вариабельны. Диагностика, как правило, основывается на наличии как минимум 60% эллиптоцитов в мазке периферической крови и семейном анамнезе подобного заболевания.
При подозрении на эти заболевания проводятся следующие тесты:
Определение осмотической хрупкости эритроцитов, при котором смешивают эритроциты с различными концентрациями физиологического раствора
Проба на аутогемолиз эрироцитов, при которой измеряют величину спонтанного гемолиза, который возникает после 48 часов стерильной инкубации

Прямой антиглобулиновый (прямая проба Кумбса) тест Прямой антиглобулиновый тест (прямая проба Кумбса). , чтобы исключить сфероцитоз вследствии аутоиммунной гемолитической анемии Аутоиммунная гемолитическая анемия Аутоиммунная гемолитическая анемия обусловлена аутоантителами, которые реагируют с эритроцитами при температуре ≥ 37 °С (гемолитическая анемия с тепловыми антителами) или 37 °С (болезнь холодовых. Прочитайте дополнительные сведения
Характерно повышение осмотической резистентности эритроцитов, однако в легких случаях как наследственного сфероцитоза, так и наследственного эллиптоцтоцитоза она может оставаться в пределах нормы, если стерильная дефибринированная кровь предварительно не инкубируется при 37 ° С в течение 24 часов. Повышается интенсивность аутогемолиза эритроцитов, который поддается коррекции путем дополнительного введения глюкозы. Прямой антиглобулиновый тест отрицательный.
Лечение
В некоторых случаях спленэктомия
Спленэктомия после проведения соответствующей вакцинации является единственным специфическим методом лечения наследственного сфероцитоза или наследственного эллиптоцитоза, однако необходимость ее применения возникает редко. Она показана пациентам с гемолизом, который вызывает симптомы или осложнения, такие как желчная колика или персистирующий апластический криз. После установлении диагноза желчекаменной болезни или при других симптомах холестаза, желчный пузырь необходимо удалить. После спленэктомии сфероцитоз сохраняется, однако повышается выживаемость клеток в кровотоке. Обычно это сопровождается разрешением симптомов, снижением выраженности анемии и ретикулоцитоза. Тем не менее осмотическая резистентность эритроцитов остается низкой.
Авторское право © 2022 Merck & Co., Inc., Rahway, NJ, США и ее аффилированные лица. Все права сохранены.
Наследственный сфероцитоз и наследственный эллиптоцитоз: причины, симптомы, диагностика, лечение

Весь контент iLive проверяется медицинскими экспертами, чтобы обеспечить максимально возможную точность и соответствие фактам.
У нас есть строгие правила по выбору источников информации и мы ссылаемся только на авторитетные сайты, академические исследовательские институты и, по возможности, доказанные медицинские исследования. Обратите внимание, что цифры в скобках ([1], [2] и т. д.) являются интерактивными ссылками на такие исследования.
Если вы считаете, что какой-либо из наших материалов является неточным, устаревшим или иным образом сомнительным, выберите его и нажмите Ctrl + Enter.
Наследственный сфероцитоз и наследственный эллиптоцитоз являются врожденными аномалиями мембраны эритроцитов. При наследственном сфероцитозе и эллиптоцитозе симптомы обычно умеренно выражены и включают анемию различной степени тяжести, желтуху и спленомегалию. Для подтверждения диагноза необходимо наличие сниженной осмотической резистентности эритроцитов и негативного прямого антиглобулинового теста. Изредка, больные моложе 45 лет нуждаются в спленэктомии.
Код по МКБ-10
Причины наследственного сфероцитоза и эллиптоцитоза
Наследственный сфероцитоз (хроническая семейная желтуха, наследственная гемолитическая желтуха, семейный сфероцитоз, сфероцитарная анемия) является аутосомно-доминантным заболеванием с различными мутациями генов. Заболевание характеризуется гемолизом эритроцитов сфероидальной формы и развитием анемии.
Патогенез
Нарушения в структуре мембранных белков приводит к аномалии эритроцитов при обоих заболеваниях. При наследственном сфероцитозе наружная оболочка клеточной мембраны уменьшена диспропорционально внутриклеточному содержимому. Уменьшение наружной оболочки клетки снижает ее эластичность, и при прохождении через микроциркуляторное русло в селезенке развивается гемолиз.
Симптомы наследственного сфероцитоза и эллиптоцитоза
Симптомы и жалобы наследственного сфероцитоза обычно умеренно выражены, анемия может быть достаточно хорошо компенсирована и не распознается до очередной вирусной инфекции, которая транзиторно снижает продукцию эритроцитов, стимулируя развитие апластического криза. Однако эти проявления исчезают с завершением инфекции. В тяжелых случаях наблюдается умеренно выраженная желтушность и симптомы анемии. Почти всегда имеется спленомегалия, которая редко приводит к абдоминальному дискомфорту. Возможно развитие гепатомегалии. Холелитиаз (пигментные камни) является обычным явлением и может вызывать характерную симптоматику. Врожденные аномалии скелета (например, «башенный» череп, полидактилия) встречаются редко. Хотя обычно у одного или более членов семьи наблюдаются признаки заболевания, некоторые семьи могут не иметь их, что вызвано различными вариантами в степени мутации генов.
Клинические особенности наследственного эллиптоцитоза аналогичны тем, что имеются при наследственном сфероцитозе, но с более легкими проявлениями.
Диагностика наследственного сфероцитоза и эллиптоцитоза
Наличие этих заболеваний предполагается у больных с необъяснимым гемолизом, особенно если имеются спленомегалия, семейный анамнез с подобными клиническими проявлениями или характерные эритроцитарные показатели. Вследствие того что эритроциты имеют сфероидальную форму и MCV в пределах нормы, средний диаметр частиц ниже нормы и эритроциты имеют сходство с микросфероцитами, МСНС увеличено. Типичным является ретикулоцитоз от 15 до 30 % и лейкоцитоз.
При подозрении на эти заболевания выполняют следующие исследования: определение осмотической резистентности эритроцитов (в котором эритроциты помещают в солевые растворы различной концентрации), тест аутогемолиза эритроцитов (измеряют уровень спонтанного гемолиза после 48 часов инкубации в стерильных условиях) для исключения сфероцитоза, обусловленного аутоиммунной гемолитической анемией, проводят прямой антиглобулиновый тест (Кумбса). Характерно снижение осмотической резистентности эритроцитов, но в легких случаях оно может быть в норме за исключением теста, при котором стерильную дефибринированную кровь инкубируют при 37 °С в течении 24 часов. Аутогемолиз эритроцитов повышен и может быть откорректирован добавлением глюкозы. Прямой антиглобулиновый тест Кумбса негативный.
К кому обратиться?
Лечение наследственного сфероцитоза и эллиптоцитоза
Единственным специфическим методом лечения при данных заболеваниях является спленэктомия, которая проводится после вакцинации пневмококковой вакциной у детей, но в ней редко возникает необходимость у взрослых. Спленэктомия показана больным моложе 45 лет, имеющим постоянный уровень гемоглобина менее 100 г/л, желтуху, печеночные колики или персистирующую аплазию. Если желчный пузырь содержит камни или имеются признаки холестаза, он должен быть удален в ходе спленэктомии. Хотя сфероцитоз сохраняется после спленэктомии, продолжительность жизни клеток в циркуляции увеличивается. Симптомы анемии и ретикулоцитоз исчезают, однако хрупкость эритроцитов остается высокой.
Наследственный сфероцитоз - Hereditary spherocytosis
Эта статья посвящена аспектам сфероцитоза, характерным для наследственной формы заболевания. Подробные сведения, относящиеся к этому и другим вариантам, см. Сфероцитоз.
Наследственный сфероцитоз аномалия красных кровяных телец, или эритроциты. Расстройство вызвано мутации в генах, относящихся к мембранным белкам, которые позволяют эритроцитам изменять форму. Аномальные эритроциты имеют сферическую форму (сфероцитоз ), а не обычный двояковогнутый диск. Дисфункциональные мембранные белки препятствуют способности клетки гибко перемещаться из артерии меньшим капилляры. Эта разница в форме также делает красные кровяные тельца более склонными к разрыв. [1] Клетки с этими дисфункциональными белками деградируют в селезенка. Эта нехватка эритроцитов приводит к гемолитическая анемия.
Впервые он был описан в 1871 году. Это наиболее частая причина наследственного гемолиза в европейских и североамериканских кавказских популяциях, с частотой 1 случай на 5000 рождений. Клиническая тяжесть HS варьируется от бессимптомного носительства до тяжелого гемолиза, поскольку заболевание проявляется неполная пенетрантность в его выражение.
Симптомы включают анемию, желтуху, спленомегалия, и усталость. [2] Кроме того, детрит разрушенных клеток крови - неконъюгированных или непрямых. билирубин - накапливается в желчный пузырь, и может вызвать пигментированные камни в желчном пузыре разрабатывать. У хронических пациентов инфекционное заболевание или другое заболевание может вызвать усиление разрушения красных кровяных телец, что приводит к появлению острых симптомов, гемолитический криз.
На мазок крови, Тела Хауэлл-Джолли можно увидеть в красных кровяных тельцах. Первичное лечение пациентов с симптоматической ГС было полным. спленэктомия, что исключает гемолитический процесс, позволяя нормальному гемоглобин, ретикулоцит и билирубин уровни.
Острые случаи могут угрожать причиной гипоксия через анемия и острый ядерная желтуха из-за высокого уровня билирубина в крови, особенно у новорожденных. Большинство случаев можно обнаружить вскоре после рождения. Взрослые с этим заболеванием должны сдать своих детей на обследование, хотя наличие болезни у детей обычно отмечается вскоре после рождения. Иногда болезнь остается незамеченной, пока ребенку не исполнится 4–5 лет. Человек также может быть носителем болезни и не проявлять признаков или симптомов болезни. Другие симптомы могут включать боль в животе, которая может привести к удалению селезенки и / или желчного пузыря.
Пациенты с сфероцитозом, гетерозиготные по гемохроматоз ген может страдать от перегрузки железом, несмотря на то, что гены гемохроматоза являются рецессивными. [3] [4]
Содержание
Презентация
Осложнения
- Гемолитический криз с более выраженной желтухой из-за ускоренного гемолиза (может быть спровоцирован инфекцией).
- Апластический криз с резким падением уровня гемоглобина и (количества ретикулоцитов) -декомпенсацией, обычно из-за остановки созревания и часто связан с мегалобластными изменениями; может быть спровоцирован инфекцией, такой как грипп, особенно с парвовирус B19. [5][6][7] вызвано повышенной потребностью костного мозга. возникают примерно у половины нелеченных пациентов. Повышенный гемолиз эритроцитов приводит к повышению уровня билирубина, потому что билирубин является продуктом распада гем. Высокий уровень билирубина должен выводиться с желчью печенью, что может вызвать образование пигментированного желчного камня, состоящего из билирубината кальция. Поскольку эти камни содержат большое количество карбонатов и фосфатов кальция, они рентгеноконтрастны и видны на рентгеновских снимках.
- Язва ноги.
- Аномально низкий гемоглобин A1C уровни. [8] Гемоглобин A1C (гликированный гемоглобин) - это тест для определения среднего уровня глюкозы в крови в течение длительного периода времени, который часто используется для оценки контроля уровня глюкозы у диабетиков. Уровни гемоглобина A1C аномально низкие, потому что продолжительность жизни красных кровяных телец сокращается, обеспечивая меньше времени для неферментативного гликозилирования гемоглобина. Таким образом, даже при высоком общем уровне сахара в крови A1C будет ниже ожидаемого.
Патофизиология
Наследственный сфероцитоз может быть аутосомно-рецессивный или же аутосомно-доминантный черта. [9] Наследственный сфероцитоз чаще всего (хотя и не исключительно) встречается в семьях Северной Европы и Японии, хотя, по оценкам, 25% случаев вызваны спонтанными мутации. Пациент имеет 50% шанс передать мутацию каждому из его / ее потомков.
Наследственный сфероцитоз вызывается различными молекулярными дефектами генов, которые кодируют белки красных кровяных телец. спектрин (альфа и бета ), анкирин, [10] группа 3 белок белок 4,2, [11] и другие белки мембран красных кровяных телец: [12]
| Тип | OMIM | Ген | Locus |
|---|---|---|---|
| HS1 | 182900 | ANK1 | 8p11.2 |
| HS2 | 182870 | СПТБ | 14q22-q23 |
| HS3 | 270970 | ЗИП | 1q21 |
| HS4 | 109270 | SLC4A1 | 17q21-q22 |
| HS5 | 612690 | EPB42 | 15q15 |
Эти белки необходимы для поддержания нормальной формы эритроцита, который представляет собой двояковогнутый диск. Наиболее часто дефектным интегрирующим белком является спектрин который отвечает за включение и связывание спектрина, поэтому его дисфункция приводит к нестабильности цитоскелета.
Первичный дефект наследственного сфероцитоза - это дефицит площади поверхности мембраны. Уменьшение площади поверхности может быть вызвано двумя различными механизмами: 1) Дефекты спектрина, анкирина (чаще всего) или белка 4.2 приводят к снижению плотности скелета мембраны, дестабилизации вышележащего липидного бислоя и высвобождению группа 3 -содержащий микровезикулы. 2) Дефекты группа 3 привести к дефициту группы 3 и потере его липид-стабилизирующего эффекта. Это приводит к потере микровезикул без трех полосок. Оба пути приводят к потере мембраны, уменьшению площади поверхности и образованию сфероцитов с пониженной деформируемостью.
Поскольку селезенка обычно нацеливается на эритроциты неправильной формы (которые обычно старше), она также разрушает сфероциты. В селезенке переход от шнуры Бильрота в синусоиды можно рассматривать как узкое место, где красные кровяные тельца должны быть гибкими, чтобы проходить через них. При наследственном сфероцитозе эритроциты не проходят и не подвергаются фагоцитозу, вызывая внесосудистый гемолиз. [13]
Диагностика
В мазок периферической крови, то красные кровяные тельца буду появляться аномально маленький и без центральной бледной области, которая присутствует в нормальных эритроцитах. Эти изменения также наблюдаются при ненаследственном сфероцитозе, но обычно они более выражены при наследственном сфероцитозе. Количество незрелых эритроцитов (количество ретикулоцитов ) будет повышен. [2] Увеличение средняя концентрация корпускулярного гемоглобина также согласуется с наследственным сфероцитозом.
В давних случаях и у пациентов, принимавших утюг добавки или получили многочисленные переливание крови, железная перегрузка может быть серьезной проблемой. Это потенциальная причина повреждение сердечной мышцы и болезнь печени. Таким образом, измерение запасов железа считается частью диагностического подхода к наследственному сфероцитозу.
An осмотическая хрупкость может помочь в диагностике. [14] В этом тесте сфероциты разрываются в жидких растворах, менее концентрированных, чем внутри эритроцитов. Это связано с повышенной проницаемостью мембраны сфероцита для соли и воды, которая попадает в концентрированную внутреннюю среду эритроцита и приводит к его разрыву. [15] Хотя испытание на осмотическую хрупкость широко считается Золотой стандарт при диагностике наследственного сфероцитоза пропускается до 25% случаев. Проточный цитометрический анализ эозин-5'-малеимида интактных эритроцитов и тест лизиса подкисленного глицерина являются двумя дополнительными вариантами для помощи в диагностике. [16]
Хотя исследования продолжаются, на данный момент нет лекарства от генетического дефекта, вызывающего наследственный сфероцитоз. [12] Текущее управление сосредоточено на вмешательствах, ограничивающих тяжесть заболевания. Варианты лечения включают:
- Спленэктомия: Как в ненаследственный сфероцитоз, острые симптомы анемия и гипербилирубинемия указывают на лечение переливание крови или обмены и хронические симптомы анемии и увеличенная селезенка указывают на диетические добавки фолиевой кислоты и спленэктомия, [17] хирургическое удаление селезенки. Спленэктомия показана в умеренных и тяжелых случаях, но не в легких случаях. [2] Чтобы снизить риск сепсис, пациентам с постспленэктомическим сфероцитозом требуется иммунизация против грипп вирус, инкапсулированные бактерии, такие как Пневмококк и менингококк, и профилактическое лечение антибиотиками. Однако использование профилактических антибиотиков, таких как пенициллин, остается спорным. [12]
- Частичная спленэктомия: Поскольку селезенка важна для защиты от инкапсулированных организмов, сепсис, вызванный инкапсулированными организмами, является возможным осложнением спленэктомии. [2] Вариант частичной спленэктомии может рассматриваться в интересах сохранения иммунной функции. Исследования результатов в настоящее время ограничены, [2] но благоприятный. [18] может быть необходимо. [12]
Эпидемиология
Наследственный сфероцитоз является наиболее распространенным заболеванием мембраны эритроцитов и поражает 1 из 2 000 человек североевропейского происхождения. [19] В соответствии с Принципы внутренней медицины Харрисона, частота составляет не менее 1 из 5000. [12]
Исследование
Экспериментальный генная терапия существует для лечения наследственного сфероцитоза у лабораторных мышей; однако это лечение еще не было опробовано на людях из-за всех рисков, связанных с генной терапией человека.
Читайте также:
